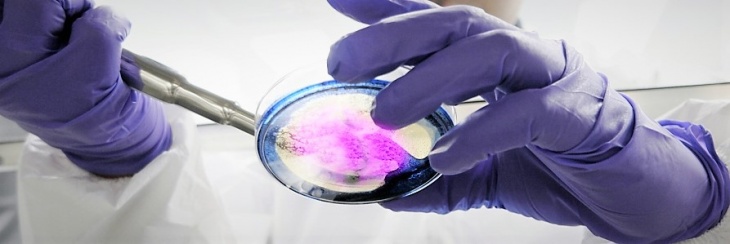

La nueva propuesta educativa de la Universidad Nacional de La Pampa (UNLPam) ya tiene el visto bueno de la Comisión Nacional de Evaluación y Acreditación Universitaria (CONEAU). Solo resta que la apruebe el Ministerio de Educación de la Nación.
La carrera es una oferta que surge del trabajo en conjunto entre las Facultades de Ciencias Agropecuarias, Ciencias Naturales y Ciencias Veterinarias, y eso le permite triplicar esfuerzos y recursos.
El dictado será completamente presencial, dado que requiere de seminarios y prácticas en laboratorios, que no se pueden hacer desde la virtualidad. La carrera incluye asignaturas como Epistemología, Estadística y Taller de Tesis. Además, se deberán completar 200 horas con cursos electivos y actividades complementarias.
La carrera está enfocada a profesionales de las ciencias biológicas, como veterinarios, ingenieros agrónomos, biólogos, ingenieros en recursos naturales y de otras carreras afines. Tendrá una carga de 500 horas, entre las diferentes asignaturas.
Los interesados pueden solicitar mayor información a: [email protected]